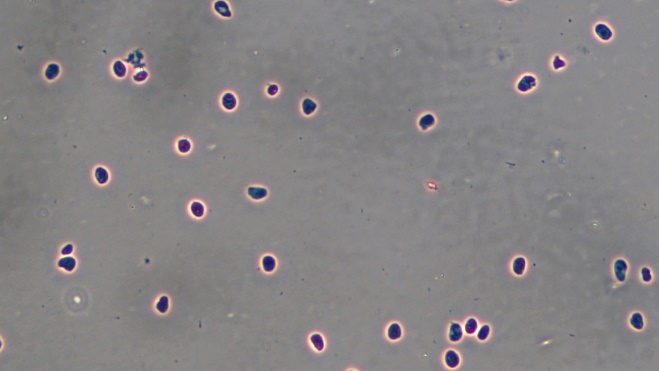

伯豪生物官网 www.shbio.com 新消息

伯豪生物提供:单细胞核测序、单细胞核测序技术服务配套的细胞核分离试剂盒,冰冻组织样本重启科研必备!

组织样本制备细胞核悬液流程适用于人或其他哺乳动物新鲜及冻存组织样本。通过裂解细胞膜,释放细胞核的同时保持细胞核膜的稳定。优化的细胞核重悬液能够有效维持细胞核膜的完整和染色质的空间结构稳定。
产品货号:52009-10;
产品规格:10rxn;
储存条件:2-8℃;
有效期限:12 个月。
伯豪生物提供:单细胞核测序、单细胞核测序技术服务配套的细胞核分离试剂盒

制备的细胞核悬液可用于:
1、染色质可及性分析(scATAC-seq/bulk ATAC-seq);
2、核转录组测序(snRNA-seq/bulk RNA-seq)等相关实验。
伯豪生物提供:单细胞核测序、单细胞核测序技术服务配套的细胞核分离试剂盒


▲小鼠脑组织

▲小鼠肝组织
▲人脑组织

▲人肝组织
伯豪生物提供:单细胞核测序、单细胞核测序技术服务配套的细胞核分离试剂

